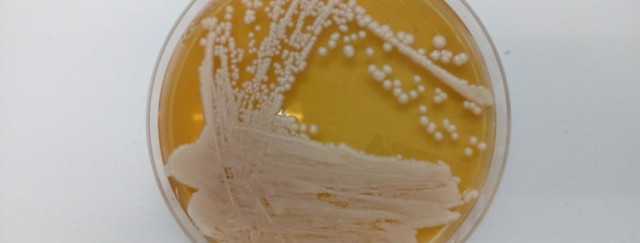

Viernes 18 de Marzo de 2022
Leído › 6716 veces
¿TE LÍAS SI TE HABLAN DE LAS LÍAS...? Sobre lías, seguro que lo has leído en un montón de etiquetas. Pero quizás no te has parado a pensar que son. Viendo que el precio de los sobre lías suele ser más alto, eso ya da idea de que debe ser mejor. Pero, ¿cómo? ¿por qué?...
¿Alguna vez dejaste un zumo de fruta recién exprimido por horas en la mesa, y luego estaba “separado” en dos? Este simple ejercicio doméstico que nos permite ver cómo los componentes más pesados del jugo se van al fondo del vaso, es también un ejemplo para identificar a las lías del jugo. Lo mismo ocurre con el mosto de uva .

Las lías son microorganismos, principalmente levaduras, que se producen durante la fermentación y que al morir se acumulan y descomponen en el fondo de los depósitos de vino junto con otras sustancias.
Técnicamente la crianza sobre lías es un proceso de envejecimiento del vino, que se produce al entrar el vino en contacto con las levaduras muertas generadas tras la fermentación alcohólica.
Durante este proceso se produce la autolisis, que consiste en que, al romperse la pared de las células de las lías, pasan al vino diversas sustancias contenidas en ellas, mejorando las características del vino.
Una forma sencilla de explicarlo es que las lías son la materia sólida que queda en el fondo del depósito de vino tras la fermentación, materia formada por levaduras muertas y otras sustancias procedentes del vino . Estas sustancias aportan mayor densidad y un aroma delicado al vino, pero también supone un proceso más complicado de elaboración que requiere más tiempo y recursos.

En esas lías o madres hay compuestos que quizás no nos interesen mucho. Pero hay otros que sí, que son beneficiosos para el vino. Y hasta para nosotros. Dependiendo de en que momento se produzcan esas madres estarán formadas por diferentes sustancias. Cuando se trata del mosto, son principalmente ácidos grasos, polisacáridos y microorganismos, entre ellos, nuestras queridas levaduras. Cuando se trata de vino, pues suelen ser levaduras ya muertas, bacterias lácticas, ácidos grasos y polifenoles.
Dentro de las lías podemos diferenciar dos tipos: lías gruesas y lías finas.
-Las lías gruesas están formadas por pepitas, pieles de la uva y tartratos del vino. Este tipo de lías pueden dar mal olor (a sucio) y amargar algo el sabor del vino por lo que se suelen descartar.
-Las lías finas son las últimas que se depositan, las que quedan en la parte superior. Las llamamos finas porque al pesar menos, tardan más en depositarse, al contrario que las gruesas que pesan más y precipitan primero.


Este proceso varía según la forma de elaboración del vino que se utilice.
Existen dos variantes: Para los vinos elaborados en barrica de madera, esta crianza se realiza mediante la técnica conocida como battonage. Consiste en remover periódicamente las lías dentro de la barrica utilizando un bastón en forma de L con el que se remueven las lías depositadas en el fondo para que se distribuyan por todo el vino.
Cuando el vino se elabora en depósitos de acero inoxidable, este proceso se realiza mediante la técnica del remontado. Periódicamente una bomba succiona el vino de la parte inferior del depósito y lo introduce de nuevo en la parte superior. Este movimiento provoca que las lías suban y se mantengan en suspensión durante más tiempo, liberando manoproteínas (forman parte de la capa externa de la pared celular de las levaduras enológicas)
Ambas técnicas suponen una elaboración más complicada, que requiere invertir más tiempo y recursos de la bodega . Añadiendo, además, que se trata de vinos con una evolución más lenta, por lo que el resultado son vinos más exclusivos y de mayor calidad.
De este modo, la crianza sobre lías ayuda a que las sustancias sólidas no se precipitan después en la botella, evitando posos, y logrando una mayor estabilidad y un menor riesgo de oxidación. Las lías consumen el oxígeno, lo que hace que aguante más en botella, consiguiendo así vinos blancos de larga duración.
Este tipo de crianza es habitual en vinos blancos, vinos espumosos (elaborados por método champenoise) se puede utilizar en vinos rosados o tintos jóvenes, pero es tan habitual. Además, las lías actúan como protectores naturales que ayudan a preservar la persistencia de los aromas sin necesidad de utilizar sulfitos, por lo que se logran vinos más naturales y ecológicos.
¿TE LIAS SI TE HABLAN DE LÍAS?
Leído › 6716 veces